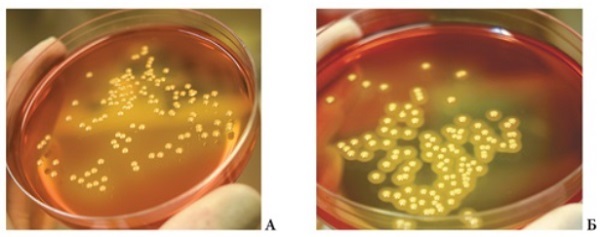

Стафилококк В Ухе Фото
Стафилококк В Ухе Фото 112 фотографий
Скинь Фото Видео
Телеграм Бот Поиск Вк По Фото
Шоколад Картинки Без Фона
Пиво 0 5 Фото
Черный Медведь Фото И Описание
Перинатальный Центр Уфа Фото
Картинки Зима Снегопад
Владимир Меньшиков Фото
Картинки 1 Сентября Дошкольникам
3d Картинки Цветов